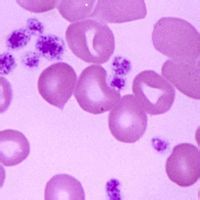
質量標準 質量標準

基本簡介
所謂標準,指的是衡量某一事物或某項工作應該達到的水平、尺度和必須遵守的規定。而規定產品質量特性應達到的技術要求,稱為“產品質量標準” (Productquality standard,Target level of product quality)。對企業來說,為了使生產經營能夠有條不紊地進行,則從原材料進廠,一直到產品銷售等各個環節,都必須有相應標準作保證。它不但包括各種技術標準,而且還包括管理標準以確保各項活動的協調進行。
質量標準
我國現行的產品質量標準,從標準的適用範圍和領域來看,主要包括:國際標準、國家標準、行業標準(或部頒標準)和企業標準等。
國際標準
國際標準是指國際標準化組織(ISO)、國際電工委員會(IEC),以及其它國際組織所制定的標準。
其中ISO是目前世界上最大的國際標準化組織,它成立於1947年,到2002年它已有117 個成員,包括117個國家和地區。ISO現已制訂10300多個標準,主要涉及各個行業各種產品的技術規範。IEC也是比較大的國際標準化組織,它主要負責電工、電子領域的標準化活動。
國家標準
國家標準是對需要在全國範圍內統一的技術要求,由國務院標準化行政主管部門制訂的標準。1988年,我國將國際標準化組織(ISO)在1987年發布的 《質量管理和質量保證標準》等國際標準仿效採用為我國國家標準,編號為GB/T10300系列.它在編寫格式、技術內容上與國際標準有較大的差別。
從1993年1月1日起,我國實施等同採用ISO9000系列標準,編號為:GB/T19000-ISO9000系列,其技術內容和編寫方法與1509000系列相同,使產品質量標準與國際同軌,以利於適應“復關”形勢。我國的國家標準是採用等同於現行的ISO9000:2000標準,編號為GB/T19000-2000系列。
行業標準
行業標準又稱為部頒標準,由國務院有關行政主管部門制定並報國務院標準行政主管部門備案,在公布國家標準之後,該項行業標準即行廢止。當某些產品沒有國家標準而又需要在全國某個行業範圍內統一的技術要求,則可以制定行業標準。
企業標準
企業標準主要是針對企業生產的產品沒有國家標準和行業標準的,制定企業標準作為組織生產的依據而產生的。企業的產品標準須報當地政府標準化行政主管部門和有關行政主管部門備案。已有國家標準或者行業標準的,國家鼓勵企業制定嚴於國家標準或者行業標準的企業標準。企業標準只能在企業內部適用。
規定產品質量特性應達到的技術要求,稱為產品質量標準。產品質量標準是產品生產、檢驗和評定質量的技術依據。
產品質量特性一般以定量表示,例如強度、硬度、化學成發等;對於難以直接定量表示的,如舒適、靈敏、操作方便等,則通過產品和零部件的試驗研究,確定若干技術參數,以間接定量反映產品質量特性。